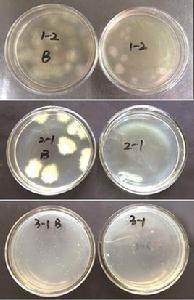
溶菌作用

定義
溶菌作用細菌細胞在外加因素的作用下,引起的解體現象。例如溶菌酶、特異性噬菌體或免疫血清加補體等都能溶菌。依抗原、抗體的種類不同可有溶血反應、溶菌反應等。溶菌反應只在某些細菌中出現(如霍亂弧菌)。套用溶血反應是補體結合反應中不可少的因素。溶血反應是由於抗原(紅血球)和抗體(溶血素)進行特異性的結合,並吸著了補體,而使紅血球在補體的作用下被溶解,於是產生了溶血現象 。
溶菌酶
溶菌酶(lysozyme)又稱胞壁質酶(muramidase)或N-乙醯胞壁質聚糖水解酶(N-acetylmuramide glycanohydrlase),是一種能水解致病菌中黏多糖的鹼性酶。主要通過破壞細胞壁中的N-乙醯胞壁酸和N-乙醯氨基葡糖之間的β-1,4糖苷鍵,使細胞壁不溶性黏多糖分解成可溶性糖肽,導致細胞壁破裂內容物逸出而使細菌溶解。溶菌酶還可與帶負電荷的病毒蛋白直接結合,與DNA、RNA、脫輔基蛋白形成復鹽,使病毒失活。因此,該酶具有抗菌、消炎、抗病毒等作用。
套用
溶菌酶對革蘭陽性菌、好氧性孢子形成菌、枯草桿菌、地衣型芽孢桿菌等都有抗菌作用,而對沒有細胞壁的人體細胞不會產生不利影響。因此,適合於各種食品的防腐。另外,該酶還能殺死腸道腐敗球菌,增加腸道抗感染力,同時還能促進嬰兒腸道雙歧乳酸桿菌增殖,促進乳酪蛋白凝乳利於消化,所以又是嬰兒食品、飲料的良好添加劑。溶菌酶對人體完全無毒、無副作用,具有抗菌、抗病毒、抗腫瘤的功效,是一種安全的天然防腐劑。在乾酪的生產中,添加一定量的溶菌酶,可防止微生物污染而引起的酪酸發酵,以保證乾酪的質量。新鮮的牛乳中含有少量的溶菌酶,每100mL約含13mg,而人乳中含有40mg/mL溶菌酶。若在鮮乳或奶粉中加入一定量的溶菌酶,不但有防腐保鮮劑的作用,而且可達到強化嬰兒乳品的目的,有利於嬰兒的健康 。
相關概念
(1)制菌作用:亦稱“抑菌作用”。利用某些物理、化學或生物因素抑制微生物生長、繁殖的作用。除去這些因素後,微生物就能恢復正常的生活力。如微生物需在一定溫度下生長、繁殖,高溫往往引起殺菌作用,低溫則起制菌作用。抗生素對微生物的抑制作用,往往是由於微生物體內的某些酶系受抑制或引起其他的代謝障礙有關。測定製菌作用的方法很多,如孢子發芽率試驗、制菌譜測定、液體生長試驗等。
(2)殺菌作用:利用某些物理、化學或生物因素使微生物失去生命活力的作用。高溫、射線、超音波、化學藥劑、抗生素、噬菌體或溶菌酶等都有這種作用。
(3)拮抗作用:亦稱“對抗作用”。指一種物質的作用被另一種物質所阻抑的現象。如代謝物質問的拮抗怍用或藥物間的拮抗作用。如兩種以上藥物共同套用時有拮抗怍用,則其產生的作用小於各種藥物單獨套用時的總和,故處方時可利用另一藥物的拮抗作用以抵消主藥的副作用。某些具有拮抗作用的藥物,亦可用於解救中毒。此外,通過一種微生物活動而抑制或殺死另一種微生物昀現象也是拮抗作用,如青黴菌產生的青黴素,能抑制某些微生物生長。生理學中某一生理過程制約另一生理過程的作用也稱拮抗作用,如伸肌反射對屈肌反射、吞咽對呼吸等 。